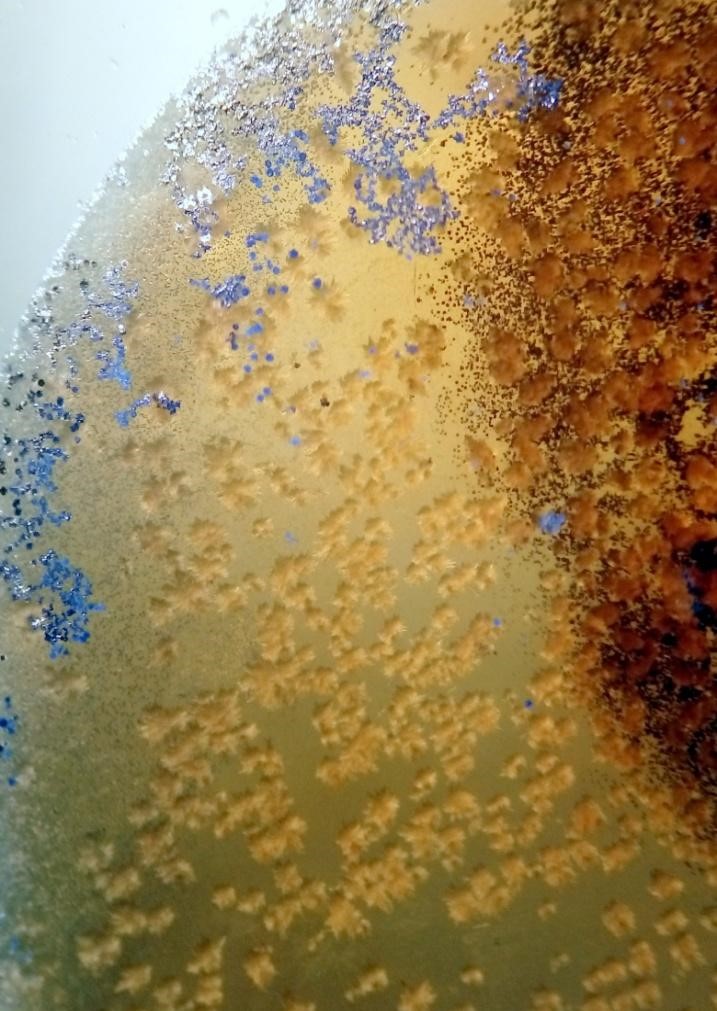

Quan els minerals i la química creen bellesa
Antoni Brun
Fa més de 65 anys que em vaig afeccionar als minerals, però mai m’havien atret els micro. Sempre m’havien semblat un trist consol, un mal substitut d’allò que ens agradaria trobar o tenir i no podem. Això fins que les anàlisis amb Raman i LIBS i les explicacions de l’Adolf Cortel em varen fer conscient de la quantitat d’informació que pot haver-hi en un tros de mineral o en una roca. L’empenta definitiva me la va donar el Paco Castro amb una visita a “Las Minicas”. A partir d’aquí vaig desempolsegar el microscopi i a fer fotos. El següent pas han estat les microanàlisis….i de l’observació per microscopi de la bellesa de les formes i colors, fruit de les reaccions d’identificació, reneix la necessitat de deixar-ho plasmat en fotografia.
El Dr. J.M. Mata, en la seva “Guia d’identificació de minerals”, explica unes anàlisis microquímiques per a identificar Fe, Cu, Zn, Co, Ni i Cd amb el reactiu de Montequi. L’observació de les reaccions i formacions de petits cristalls mitjançant el microscopi em varen deixar embadalit per la seva bellesa. Tot seguit varen venir les fotos i el desig de compartir-ho.
No aconsello fer aquest tipus d’anàlisi a menys que tingueu formació en química i el material de protecció necessari, ja que els productes a utilitzar són corrosius, molt tòxics i, endemés, si hi ha sulfurs es formarà NO, que s’oxida d’immediat a NO2 que és verinós.
CRISTALLS FORMATS PER REACCIÓ AMB EL MERCURITIOCIANAT AMÒNIC
El zinc forma cristalls com plomes i encreuats de mercuritiocianat de zinc. Són blancs, però agafen un color violeta per la presència de Cu2+. De fet, la presència de Cu2+ és un sistema que molt temps enrere s’utilitzava per a detectar el zinc. Pot arribar a negre violaci per formació de mercuritiocianat de coure anhidre. La presencia de Fe3+ els dóna un color rosat.
El coure, si està sense Zn, presenta cristalls de color groc a groc verdós. Si hi ha Zn tenyirà els cristalls del mercuritiocianat de zinc amb tints violacis, tal com està descrit en el paràgraf anterior.
El cobalt precipita cristalls blaus, amb tendència a anar a les voreres de la gota d’assaig.
El níquel dóna un precipitat de boletes blanques i punxegudes. Com el ferro ja està com Fe3+, no interferiran i podem comprovar la presència del níquel alcalinitzant lleugerament amb amoníac i afegint una gota de dimetilglioxima en solució d’etanol. El color rosat o vermellós serà la confirmació.
El ferro no dóna precipitat, però tenyeix la gota d’una intensa coloració roig sang. Com ja sabem, el Fe ens tintarà de rosat els cristalls blancs del mercuritiocianurat de zinc.
La formació de cristalls no sempre és immediata; de vegades ens caldrà esperar una mica.
No adjunto cap fotografia de l’assaig del ferro, ja que només podem veure la intensa coloració roig sang, però cap cristall. En totes les mostres que he utilitzat em surt ferro; està per tot arreu. Per això vaig escollir la mostra d’esfalerita de la mina “Ana” (Parzán, Osca) que era de color molt més clar, menys ferro, que les del Pics d’Europa i, per descomptat, que les del nostre Pirineu. No disposava de NaF per a neutralitzar la coloració deguda al ferro. La veritat és que ha fet molta nosa i ha impedit visualitzar bé els petits cristalls que es formen.
La presència del Ni l’he confirmat amb la dimetilglioxima.
El Cu de la malaquita donava ja el típic color verd blavós a l’atacar la mostra amb el HNO3.
El Co de l’eritrina donava un color rosat al ser atacat amb el HNO3 concentrat.
Totes les mostres emprades són minerals trobats sobre el terreny; per tant, quasi sempre veurem que hi ha de tot una mica…

Com a cloenda, uns cristalls del mercuritiocianat amònic
FONTS D’INFORMACIÓ:
- Josep Maria Mata i Perelló, Joaquim Sanz i Balagué. (1988) “Guia d’identificació de minerals.” Parcir, Edicions Selectes. ISBN: 84-86538-11-4.
- Fernando Burriel, Felipe Lucena Conde, Siro Arribas Gimeno. (1952) “Química Analítica Cualitativa“ Ediciones Paraninfo.
- Enrique Monllor Matarrodona. (1946) “Nuevas consideraciones sobre la reacción analítica. Montequi”. Universidad de Murcia (Servicio de Publicaciones). ISSN 0365-7973.
- Cesar Menor Salván (2011) “La microscopía química clásica: una técnica didáctica y de bajo coste para la identificación de metales en minerales” ACOPIOS2011 V2:29-58, MTIEDIT ISSN 2171-7788.